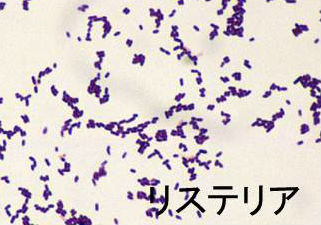
リステリア リステリア

食中毒菌(サルモネラ,エルシニア,カンピロバクター,リステリア,ビブリオ・バルニフィカス)と甲状腺、糖尿病[橋本病 バセドウ病 長崎甲状腺クリニック 大阪]
長崎甲状腺クリニック(大阪)は甲状腺専門クリニックに特化するため、糖尿病内科を廃止しました。
また、長崎甲状腺クリニック(大阪)は、感染症の診療を行っておりません。
糖尿病:専門の検査治療[橋本病 バセドウ病 甲状腺超音波エコー 長崎甲状腺クリニック大阪]
甲状腺専門・内分泌代謝・動脈硬化の長崎甲状腺クリニック(大阪府大阪市東住吉区)院長が海外・国内論文に眼を通して得た知見、院長自身が大阪市立大学 代謝内分泌内科で得た知識・経験・行った研究、甲状腺学会で入手した知見です。
長崎甲状腺クリニック(大阪)以外の写真・図表はPubMed等において学術目的で使用可能なもの(Creative Commons License)、public health目的で官公庁・非営利団体等が公表したものを一部改変しています。引用元に感謝いたします。尚、本ページは長崎甲状腺クリニック(大阪)の経費で非営利的に運営されており、広告収入は一切得ておりません。
甲状腺・動脈硬化・内分泌代謝・糖尿病に御用の方は 甲状腺編 動脈硬化編 内分泌代謝(副甲状腺/副腎/下垂体/妊娠・不妊等 糖尿病編 をクリックください
Summary
生卵・生肉の食中毒菌サルモネラによる急性化膿性甲状腺炎は①50歳前後の男女に多い②下咽頭梨状窩瘻の無い右側に多い③血行性感染で治癒後の再発は無い。低温細菌、エルシニア菌体表面の蛋白質とTSH受容体のアミノ酸構造が類似し、エルシニア抗体とTSH受容体抗体(TRAb)が交差反応して甲状腺機能亢進症/バセドウ病発症の説あり。カンピロバクター食中毒(生肉感染、カンピロバクター腸炎)、リステリア(リステリア髄膜炎)、ビブリオ・バルニフィカス(生牡蠣・刺身感染、壊死性筋膜炎)は糖尿病、高齢者、妊婦、乳幼児など免疫低下している人で重症化。
Keywords
食中毒,サルモネラ,甲状腺,エルシニア,バセドウ病,カンピロバクター,リステリア,ビブリオ・バルニフィカス,糖尿病,免疫低下
厚生労働省食中毒統計によると、令和6年度の食中毒発生件数は年間1,037件(患者:14,229人、死者:3人)で、細菌・ウイルス性食中毒は過半数の597件(患者:13,054人、死者:0人)でした。
食品衛生法第58 条により「食中毒患者を診断し、または死体を検案した医師は、直ちに(24 時間以内に)最寄りの保健所長に届け出る」ことが義務付けられています。
食中毒患者数(2022年度)で最も多いのはノロウイルス感染症、次いで糖尿病ガス壊疽の起因菌であるウェルシュ菌(Clostridium perfringens)です。
厚生労働省は、8月を「食品衛生月間」と定め、食中毒予防の三原則「(使い分けて)つけない」「(低温保存で)増やさない」「(加熱調理で)やっつける」を呼びかけています。
農林水産省のHPでは、お弁当づくりによる食中毒を予防する方法として、
- 菌の繁殖を防ぐため、ごはんやおかずを冷やしてから詰める
- 菌が移るのを防ぐため、おかずの汁気をよく切る、仕切りや盛り付けカップを使用する
のを推奨しています。
厚生労働省による避難所における感染症発生のリスクアセスメントで、新型コロナウイルス感染症と食品媒介性感染症(感染性胃腸炎、食中毒)リスク評価はもっとも高い「3」です。高温多湿の環境下、十分に衛生管理ができない場所で、食材、弁当などが感染源になる危険性があります。避難所での感染性胃腸炎や食中毒が過去に発生しています。
早い話、免疫不全の人は、生ものは食べずに火を通す事です。これは有史以来の人間の知恵です。どんな病原菌も高熱で死滅します。果物も、野菜も過熱すれば、o-157も、サルモネラ菌もすべて死滅し、感染は起こりません。
「舞姫」で有名な文豪、森鴎外の本職は医師であり、細菌学を専攻していました。そのため、雑菌に警戒心が強く、生水を飲まず、果物も煮て食べました。
サルモネラによる急性化膿性甲状腺炎
なんと、なんと、サルモネラによる急性化膿性甲状腺炎が報告されています[耳鼻咽喉科臨床 2003;96(7)629-635]。50歳女性で、下咽頭梨状窩瘻[かいんとうりじょうかろう]は無く、胃腸炎の既往も無いのに、Salmonella Anatumの感染だったそうです。
過去のサルモネラによる急性化膿性甲状腺炎の報告では、Salmonella Typhi、Salmonella Enteritidis、Salmonella Braudeuburg、Salmonella Paratyphi A、Salmonella Cholerae、Salmonella Panamaが同定されています。(Clin Infect Dis. 1995 Jan;20(1):196.)
また、それらの報告例は、
- 50歳前後の男女に多い(下咽頭梨状窩瘻[かいんとうりじょうかろう]は子供に多い)
- 下咽頭梨状窩瘻[かいんとうりじょうかろう]の無い右側に多い
- 治癒後の再発は無い(下咽頭梨状窩瘻[かいんとうりじょうかろう]は、塞ぐか、摘出しない限り、高率に再発)
ため、血行性感染が考えられます。
では、一体どこからサルモネラ菌が体内に侵入したのでしょうか?胃腸炎は無いので経口感染とは考えにくい、汚染された卵や食品を食べた線は薄くなります。ならば、直接、傷口から侵入した可能性が高くなります。①汚染された食材を料理した、あるいは②カメ関連サルモネラ症(次項)が考えられます。
カメ関連サルモネラ症
カメ等の爬虫類は糞便中のサルモネラ保菌率が50~90%と異常に高く(Vet Microbiol 84: 79-91, 2002)、亀自体を触ったり、水槽を掃除したりすれば感染する可能性があります。日本の生態系の破壊者、特定外来生物ミドリガメ(ミシシッピアカミミガメ)から感染する確率が最も高いと予測され、2022年、ようやく全面輸入禁止になりました(池の水全部抜く大作戦を見てください!)。遅すぎる、行政は何やっとった!
腸チフス
衛生状態の良い日本で、めっきり見かけなくなった腸チフスは、チフス菌(Salmonella Typhi)による感染症です。前述の急性化膿性甲状腺炎の起因菌としても報告されています[Med J Malaysia. 1998 Mar;53(1):109-11.]。チフス菌に汚染された水、氷、食べものから経口感染します。腸チフスと言っても、下痢はあまりなく、チフス菌が腸から血液中に侵入するため、急性化膿性甲状腺炎が起きるのです。
一般的な腸チフス症状は、1~3週間の潜伏期の後、高熱(稽留熱;日差1℃以内で高熱が長時間続く)、高熱時の淡いピンク色の発疹、便秘などです。熱が高い割に脈が遅い(徐脈)のが特徴。時に腸出血、腸穿孔もあります。
甲状腺乳頭癌の転移リンパ節にチフス菌(Salmonella Typhi)が感染(嚢胞内感染)し、サルモネラ誘発性頸部膿瘍を発生した報告があります。[Case Rep Med. 2017;2017:5670429.]
サルモネラ菌で可逆性の脳梁膨大部病変を伴う軽症脳炎/脳症 (MERS)
サルモネラ菌で可逆性の脳梁膨大部病変を伴う軽症脳炎/脳症 (MERS) を引き起こす可能性があります。
エルシニアは5℃以下でも増殖する低温細菌です。ブタ・ウシ・ヒツジ・ウマ、犬猫、モルモットなど動物の糞で汚染されたで食肉(豚肉)、飲料水、井戸水が感染源。
主にYersinia enterocolitica が原因で、24~48 時間の潜伏期の後、発熱とともに発疹が出る発疹性の食中毒。虫垂炎のような猛烈な腹痛がおこります。
「エルシニア腸炎を併発し治療に苦慮した高血圧・糖尿病合併妊娠の一例 」「エルシニア感染症を伴った糖尿病合併妊娠の1例」など糖尿病妊婦での報告が多くみられます。
甲状腺機能亢進症/バセドウ病の発症に関与
エルシニア(Yersinia enterocolitica) 菌体表面の外膜蛋白質とTSH受容体のアミノ酸構造が類似し、エルシニア抗体とTSH受容体抗体(TRAb)が交差反応をおこすのが、甲状腺機能亢進症/バセドウ病発症の1因とする説があります[Science. 1983 Mar 18;219(4590):1331-3.][Endocrinol Jpn. 1989 Jun;36(3):381-6.](J Clin Endocrinol Metab 95:4012-4020, 2010) 。
バセドウ病患者のエルシニア(Yersinia enterocolitica)抗体保有率は47~76%で、過去に感作が成立している事が多いとされます(Thyroid 12:613-617, 2002)。
エルシニア(Yersinia enterocolitica)の菌血症を伴う甲状腺クリーゼ
エルシニア(Yersinia enterocoliticaが甲状腺機能亢進症/バセドウ病の発症に関与すると言う仮説を裏付ける様に、エルシニア(Yersinia enterocolitica)の菌血症を伴った甲状腺クリーゼの症例報告があります。(小児感染免疫 2012; 24(3):258-261)
ペスト菌(Yersinia pestis)
ペスト菌(Yersinia pestis)もエルシニアの一種で、1300年代半ばの中世ヨーロッパで猛威を振るい(パンデミック)、黒死病と恐れられました。当時のヨーロッパ人口に対する1/3(約2500万人)がペストで死亡しました。
当時の絵画を見ると、死体を片付ける人たちは、皆マスクを着用して、直接死体を触らない様にしています。
「吸血鬼ノスフェラトゥ」という異彩を放つドラキュラ映画の名作があります。これは黒死病の蔓延と、原因となるネズミの異常発生が吸血鬼の仕業(ドラキュラ伯爵の棺桶からネズミが湧いて出た)に見立てています。ペスト菌が日光や熱に弱いのは吸血鬼と共通です。印象的なのは、死から逃れられないと開き直り、ネズミがウヨウヨいる中で会食(最後の晩餐)を楽しむ人々の姿です。
1894年、香港で流行していたペストの調査へ行った北里柴三郎(2024年から1000円札の肖像画)は、患者の血液からペスト菌を発見します。さらに、ペスト菌を媒介するのがネズミであるのを突き止め、ネズミを駆除してペストを終息させました。
しかしペスト感染症は消え去った訳でなく、現在も地球上で毎年、約1000-3000人の患者が発生しています(WHOの統計による)が報告しています。ペストは現在、日本では絶滅していますが、よく映画や医療系の漫画(ドクターKなど)で細菌兵器として製造されたペスト菌が登場します。
ネズミとネズミノミ両方がペスト菌を持っていて、直接ヒトに、あるいはネコやイヌから感染します(横浜市HPより)。ペスト菌に接触した可能性のある人は、抗生物質の予防的投与[ドキシサイクリン(ビブラマイシン®)あるいはシプロフロキサシン[シプロキサン®、チラーヂンSの吸収障害(薬剤性チラーヂンS吸収障害)をおこす]の7日間投与]が勧められます。

急性大腸型の感染性腸炎で発生件数が最も多いカンピロバクター食中毒(カンピロバクター腸炎)は、鶏レバーやささみの刺身(鳥刺し)、鳥わさ/鶏のタタキ、加熱不足の調理品、鶏卵、牛生レバーが原因。生の鶏肉を水で洗うとカンピロバクターを含んだ汚染水が飛散し、シンクや周りの食材が汚染される危険があります。生の鶏肉の水気はキッチンペーパーなどで拭き取るのが良い。
厚生労働省の平成26年度報告によると、鶏もも肉、鶏むね肉のカンピロバクター汚染率は約40%です。、
同じ食材ではサルモネラ菌、大腸菌、リステリアなどの可能性もあり、これらを加えると細菌汚染率はさらに大きくなります。
カンピロバクター食中毒(カンピロバクター腸炎)の潜伏期間は2~7日。
カンピロバクターは食中毒の病原体として、
- 国内ではノロウイルス(ウイルス性小腸型腸炎)と並んで多い
- 旅行者下痢症の起炎菌としても、毒素原性大腸菌に次いで多く、東南アジアで感染してくる可能性あり
起因菌はCampylobacter jejuniとCampylobacter coliで、前者が多い。
糖尿病患者、高齢者、妊婦、乳幼児など免疫低下している人は重症化。
カンピロバクター食中毒(カンピロバクター腸炎)の潜伏期間は2~7日ですが、2週間弱のことがあります。症状は、
- 発熱(細菌性の大腸型腸炎)
- 腹痛
- 水様下痢
- 悪心はあるが、嘔吐はない(細菌性の大腸型腸炎)
便グラム(Gram)染色・便培養を行いつつ、カンピロバクター食中毒(カンピロバクター腸炎)はマクロライド剤(クラリスロマイシンなど)で治療します。便グラム(Gram)染色では炎症による白血球と、小型のらせん状のグラム(Gram)陰性桿菌を認めれば、培養結果を待たずにカンピロバクター腸炎と診断できます。
カンピロバクター 便グラム(Gram)染色[BMJ Case Rep. 2014 Jan 28;2014:bcr2013202876.]
ただし、マクロライド剤自体に腹痛、下痢、嘔吐の副作用があるので、腸炎症状を悪化させる可能性もあります。ニューキノロン剤は消化器系の副作用は少ないが、ニューキノロン耐性カンピロバクターも増えているので効果が無い可能性もあります。
軽症のカンピロバクター腸炎は自然治癒します。
カンピロバクター腸炎が完治後、ギランバレー症候群を発症することがあります[J Autoimmun. 2005;25 Suppl:74-80.]。
カンピロバクター腸炎の予防は、食肉を十分に加熱調理(中心部を75℃以上で1分間以上加熱)することです。
Campylobacter fetusは稀な日和見感染症の原因菌であるが、
- 甲状腺機能亢進症患者で甲状腺膿瘍を形成した[Acta Clin Belg. 2007 Mar-Apr;62(2):130-3.]
- のう胞性腫瘍(嚢胞性腫瘍)内感染による急性化膿性甲状腺炎をおこした[IDCases. 2019 Dec 19;19:e00681.]
報告があります。
ビブリオ・バルニフィカス(vibrio vulnificus)は、暖かい海水中の貝類、甲殻類、魚介類の表面に付着、
- 生牡蠣・刺身の摂取
- 皮膚の創傷に、汚染された海水が掛かる
- 海岸や岩場を裸足で歩き、貝殻を踏む
- 山奥の温泉でも海水と同じ成分なら傷口から入る
などで感染します。肝硬変や免疫力低下した患者で重症化し、敗血症・壊死性筋膜炎をおこすと致死率50~70%。
人食いバクテリ、劇症型溶血性連鎖球菌感染症(Toxic Shock-like Syndrome)による壊死性筋膜炎と鑑別要。
リステリア菌は特徴的なグラム陽性杆菌(長方形の菌)です。生野菜や生肉、メロンなどの果物、低温殺菌されていない乳製品・チーズを介して感染、食品製造工場における二次汚染もあります。
健康成人は軽い胃腸炎で済みますが、高齢者、糖尿病や甲状腺機能低下症・下垂体機能低下症の免疫不全者、妊婦、乳幼児は髄膜炎や敗血症をおこして重篤(重症)化。50-60歳以上の細菌性髄膜炎は、肺炎球菌、髄膜炎菌の他、リステリア菌を考えねばなりません。[Open Life Sci. 2023 Nov 8;18(1):20220738.]
中枢神経系のリステリア菌感染症は致命的で、脳脊髄液培養は陽性率が低い。
自己免疫性脳炎および脱髄疾患が合併もしくは誘発されることがある[Front Public Health. 2022 May 12;10:848868.]。
黄色ブドウ球菌食中毒は、耐熱性毒素のエンテロトキシンによる毒素型食中毒なので、食前加熱は無効。ちなみに、食前加熱が無効な食中毒としては、他にフグ中毒(テトロドトキシン)があります。
日本では、薬剤耐性菌が年々増加しており、黄色ブドウ球菌と大腸菌の問題が大きい。薬剤耐性大腸菌、特にフルオロキノロン耐性大腸菌(FQREC)による菌血症の死亡者数は、2019年に年間約3,900~4,000人と推定されます。
2019年のJANIS(厚生労働省院内感染対策サーベイランス事業)において、大腸菌のレボフロキサシン(クラビット®)耐性率は約40%でした。
病原性大腸菌は、肉類だけでなく生野菜(カイワレ大根、もやしなど)からも感染します。また、汚染されたプールの水からも感染します。潜伏期間は12~24 時間。病原性大腸菌の中でも、腸管出血性大腸菌(ベロ毒素産生性大腸菌)は溶血性尿毒症症候群(hemolytic uremic syndrome:HUS)を引きおこすため、第3類感染症(全数把握、診断後直ちに届け出)・学校保健安全法の第3種学校感染症(学校医その他の医師において感染の恐れがないと認めるまで出席停止)に指定されています。溶血性尿毒症症候群(HUS)は小児に発症しやすく、
- 微小血管障害性溶血性貧血;微小血管内に血栓が多発し、通過する赤血球が破砕される(破砕赤血球が増加)
- 血小板減少
- 急性腎不全
に至ります。甲状腺と関連する非典型溶血性尿毒症症候群(atypical hemolytic uremic syndrome :aHUS)は、病原性大腸菌と関係ありません。
大腸菌(E.coli)が原因で、ヒト免疫不全ウイルス(HIV)感染症女性に発症した急性化膿性甲状腺炎の報告があります[Eur J Case Rep Intern Med. 2021 Nov 19;8(11):003009.]。
その他、大腸菌(E.coli)による急性化膿性甲状腺炎、甲状腺膿瘍の報告は複数あります[J Community Hosp Intern Med Perspect. 2019 Apr 12;9(2):159-161.][Pan Afr Med J. 2012;11:42.]
コレラ(Cholera、虎狼痢:ころり)は毒素産生性のコレラ菌によって引き起こされる急性細菌性腸感染症です。南アジア・東南アジア・アフリカで感染して日本に持ち込まれます。コレラ菌に汚染された不衛生な水や食べ物から経口感染、ツアー客に振舞われた氷上のカットフルーツやウェルカムドリンクから感染した事例も。コレラ菌感染では、米のとぎ汁様の激しい下痢・嘔吐による脱水・低カリウム血症(下痢の低カリウム血症・嘔吐・利尿薬・下痢の低カリウム血症)から、治療しなければ数時間で死に至ることもあります。
コレラ毒素はTSHやTRAb同様、甲状腺濾胞細胞のアデニル酸シクラーゼを刺激します[Endocrinology. 1980 Dec;107(6):2051-4.]。
コレラは世界中で大流行を繰り返しました。日本でも江戸時代から明治時代にかけて数回大流行し、死者は合計約37万人に及び、ころりと死ぬため虎狼痢(ころり)と呼ばれました。
ヨーロッパでも、コレラ菌で汚染された上水道や井戸水が原因で大流行が起きました。下の絵画は、ベルギー・ブリュッセルの美術館で手に入れた絵葉書です。地下墓地のMort du cholera(コレラで死亡)と書かれた棺桶から、死んだと思われて埋葬された人が出ようとしています。脱水で意識がなく、感染の危険もあるため、性急に死亡判定されたのでしょう。乱雑に積み重ねられた棺桶が大量の死者が出ていることを物語っています。
養殖ムラサキイガイ(ムール貝)の記憶喪失性貝毒ドウモイ酸(domoic acid)が原因で、記憶喪失を特徴とする食中毒が起こります。ドウモイ酸は、脳の海馬・視床・扁桃体の脳神経細胞を破壊します。
1987年11月、カナダのプリンスエドワード島で発生した記憶喪失性食中毒は有名(患者数103名、死者数3名)。日本での報告は、まだありません。
ドウモイ酸は、セロトニン作動系を介して血清TSHおよび甲状腺ホルモン(T4、T3)値に影響するとされます。[Endocr Res. 1995 Aug;21(3):671-80.]
馬は牛や豚と比べ体温が高く(約40度)、細菌が繁殖し難いため、刺身(馬刺し)でも食中毒をおこす危険は少ないとされます。馬刺しは主に、たてがみの付け根にある皮下脂肪(コウネ、コーネ)です。
しかしながら、馬刺しによる食中毒が全くないわけではありません。馬刺しによる食中毒は、
- サルコシスティス・フェアリー(Sarcocystis fayeri)という寄生虫(住肉胞子虫);食後数時間で下痢や嘔吐。人には寄生しないため一過性で終わることが多く、通常は速やかに回復します。−20℃~−40℃で冷凍処理後、ペプシン処理で殺虫
- 腸管出血性大腸菌(ベロ毒素産生性大腸菌);重症化する可能性。腸管内に存在する菌で、食肉に処理する過程で汚染。
が原因で発生します。一方、腸管出血性大腸菌(ベロ毒素産生性大腸菌)は溶血性尿毒症症候群(HUS)を引きおこし、重症化する可能性があるため注意が必要です。
食中毒を疑ってもアセトン血性嘔吐症(周期性嘔吐症)の事があります。アセトン血性嘔吐症(周期性嘔吐症)は2~10 歳児に好発。幼児は蓄積エネルギーが少ないため、絶食で容易に低血糖症、および異化亢進によるケトン血症を来します(ケトン性低血糖症)。
甲状腺関連の上記以外の検査・治療 長崎甲状腺クリニック(大阪)
- 甲状腺編
- 甲状腺編 part2
- 内分泌代謝(副甲状腺/副腎/下垂体/妊娠・不妊等
も御覧ください
長崎甲状腺クリニック(大阪)とは
長崎甲状腺クリニック(大阪)は日本甲状腺学会認定 甲状腺専門医[橋本病,バセドウ病,甲状腺超音波(エコー)検査など]による甲状腺専門クリニック。大阪府大阪市東住吉区にあります。平野区,住吉区,阿倍野区,住之江区,松原市,堺市,羽曳野市,八尾市,天王寺区,東大阪市,生野区,浪速区も近く。